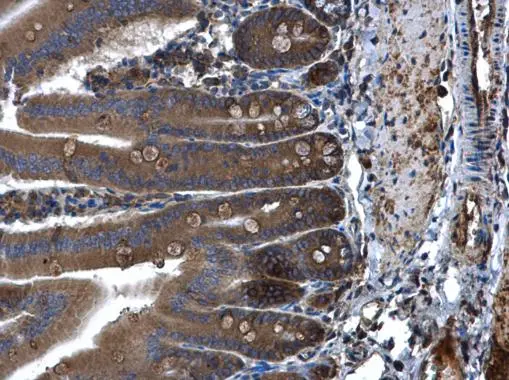
PLA2G4A antibody detects PLA2G4A protein at cytoplasm in mouse duodenum by immunohistochemical analysis. Sample: Paraffin-embedded mouse duodenum. PLA2G4A antibody (GTX110218) diluted at 1:500. 
 Antigen Retrieval: Citrate buffer, pH 6.0, 15 min

Immunofluorescence analysis of paraformaldehyde-fixed HeLa, using cPLA 2 (GTX110218) antibody at 1:200 dilution.
PLA2G4A antibody
GTX110218
ApplicationsImmunoFluorescence, Western Blot, ImmunoCytoChemistry, ImmunoHistoChemistry, ImmunoHistoChemistry Paraffin
Product group Antibodies
ReactivityHuman, Mouse
TargetPLA2G4A
Overview
- SupplierGeneTex
- Product NamePLA2G4A antibody
- Delivery Days Customer9
- Application Supplier NoteWB: 1:500-1:3000. ICC/IF: 1:100-1:1000. IHC-P: 1:100-1:1000. *Optimal dilutions/concentrations should be determined by the researcher.Not tested in other applications.
- ApplicationsImmunoFluorescence, Western Blot, ImmunoCytoChemistry, ImmunoHistoChemistry, ImmunoHistoChemistry Paraffin
- CertificationResearch Use Only
- ClonalityPolyclonal
- Concentration0.3 mg/ml
- ConjugateUnconjugated
- Gene ID5321
- Target namePLA2G4A
- Target descriptionphospholipase A2 group IVA
- Target synonymsGURDP, PLA2G4, cPLA2, cPLA2-alpha, cytosolic phospholipase A2, calcium-dependent phospholipid-binding protein, lysophospholipase, phosphatidylcholine 2-acylhydrolase, phospholipase A2, group IVA (cytosolic, calcium-dependent)
- HostRabbit
- IsotypeIgG
- Protein IDP47712
- Protein NameCytosolic phospholipase A2
- Scientific DescriptionThis gene encodes a member of the cytosolic phospholipase A2 group IV family. The enzyme catalyzes the hydrolysis of membrane phospholipids to release arachidonic acid which is subsequently metabolized into eicosanoids. Eicosanoids, including prostaglandins and leukotrienes, are lipid-based cellular hormones that regulate hemodynamics, inflammatory responses, and other intracellular pathways. The hydrolysis reaction also produces lysophospholipids that are converted into platelet-activating factor. The enzyme is activated by increased intracellular Ca(2+) levels and phosphorylation, resulting in its translocation from the cytosol and nucleus to perinuclear membrane vesicles. [provided by RefSeq]
- ReactivityHuman, Mouse
- Storage Instruction-20°C or -80°C,2°C to 8°C
- UNSPSC41116161